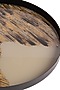

For best prices and early deliveries, WhatsApp us at. 918488070070

VIEW HI-RES IMAGES


Gold & Grey Glass Round Serving Tray
Price Details
Maximum Retail Price
(Incl. of taxes, excl. custom duties)Discount
Selling Price
(Incl. of taxes, excl. custom duties)Incl. of taxes, excl. custom duties
PRODUCT DESCRIPTION
This gold and black round tray crafted in glass with a slim metal frame are designed to add a touch of elegance to any occasion. The slim metal frame provides a sturdy tray base and adds a touch of sophistication. The round shape of the tray makes it perfect for serving drinks, appetizers, and desserts, while the beautiful gold and black design adds a touch of luxury. This round tray is the perfect addition to your serving ware collection.
PRODUCT CODE
HHCC052370
Features
SHIPPING INFORMATION
This product will be shipped to you after 2-3 Weeks from the date of order placed. All custom made orders are not returnable.
Disclaimer
Customisations
Same style in a bespoke color
Don’t want the whole set?
Buy only one item from the look
Live Product Preview
Call us to see the product live.
Early Delivery
Need the product sooner?
Do you need help with customisation or shipping of this product?